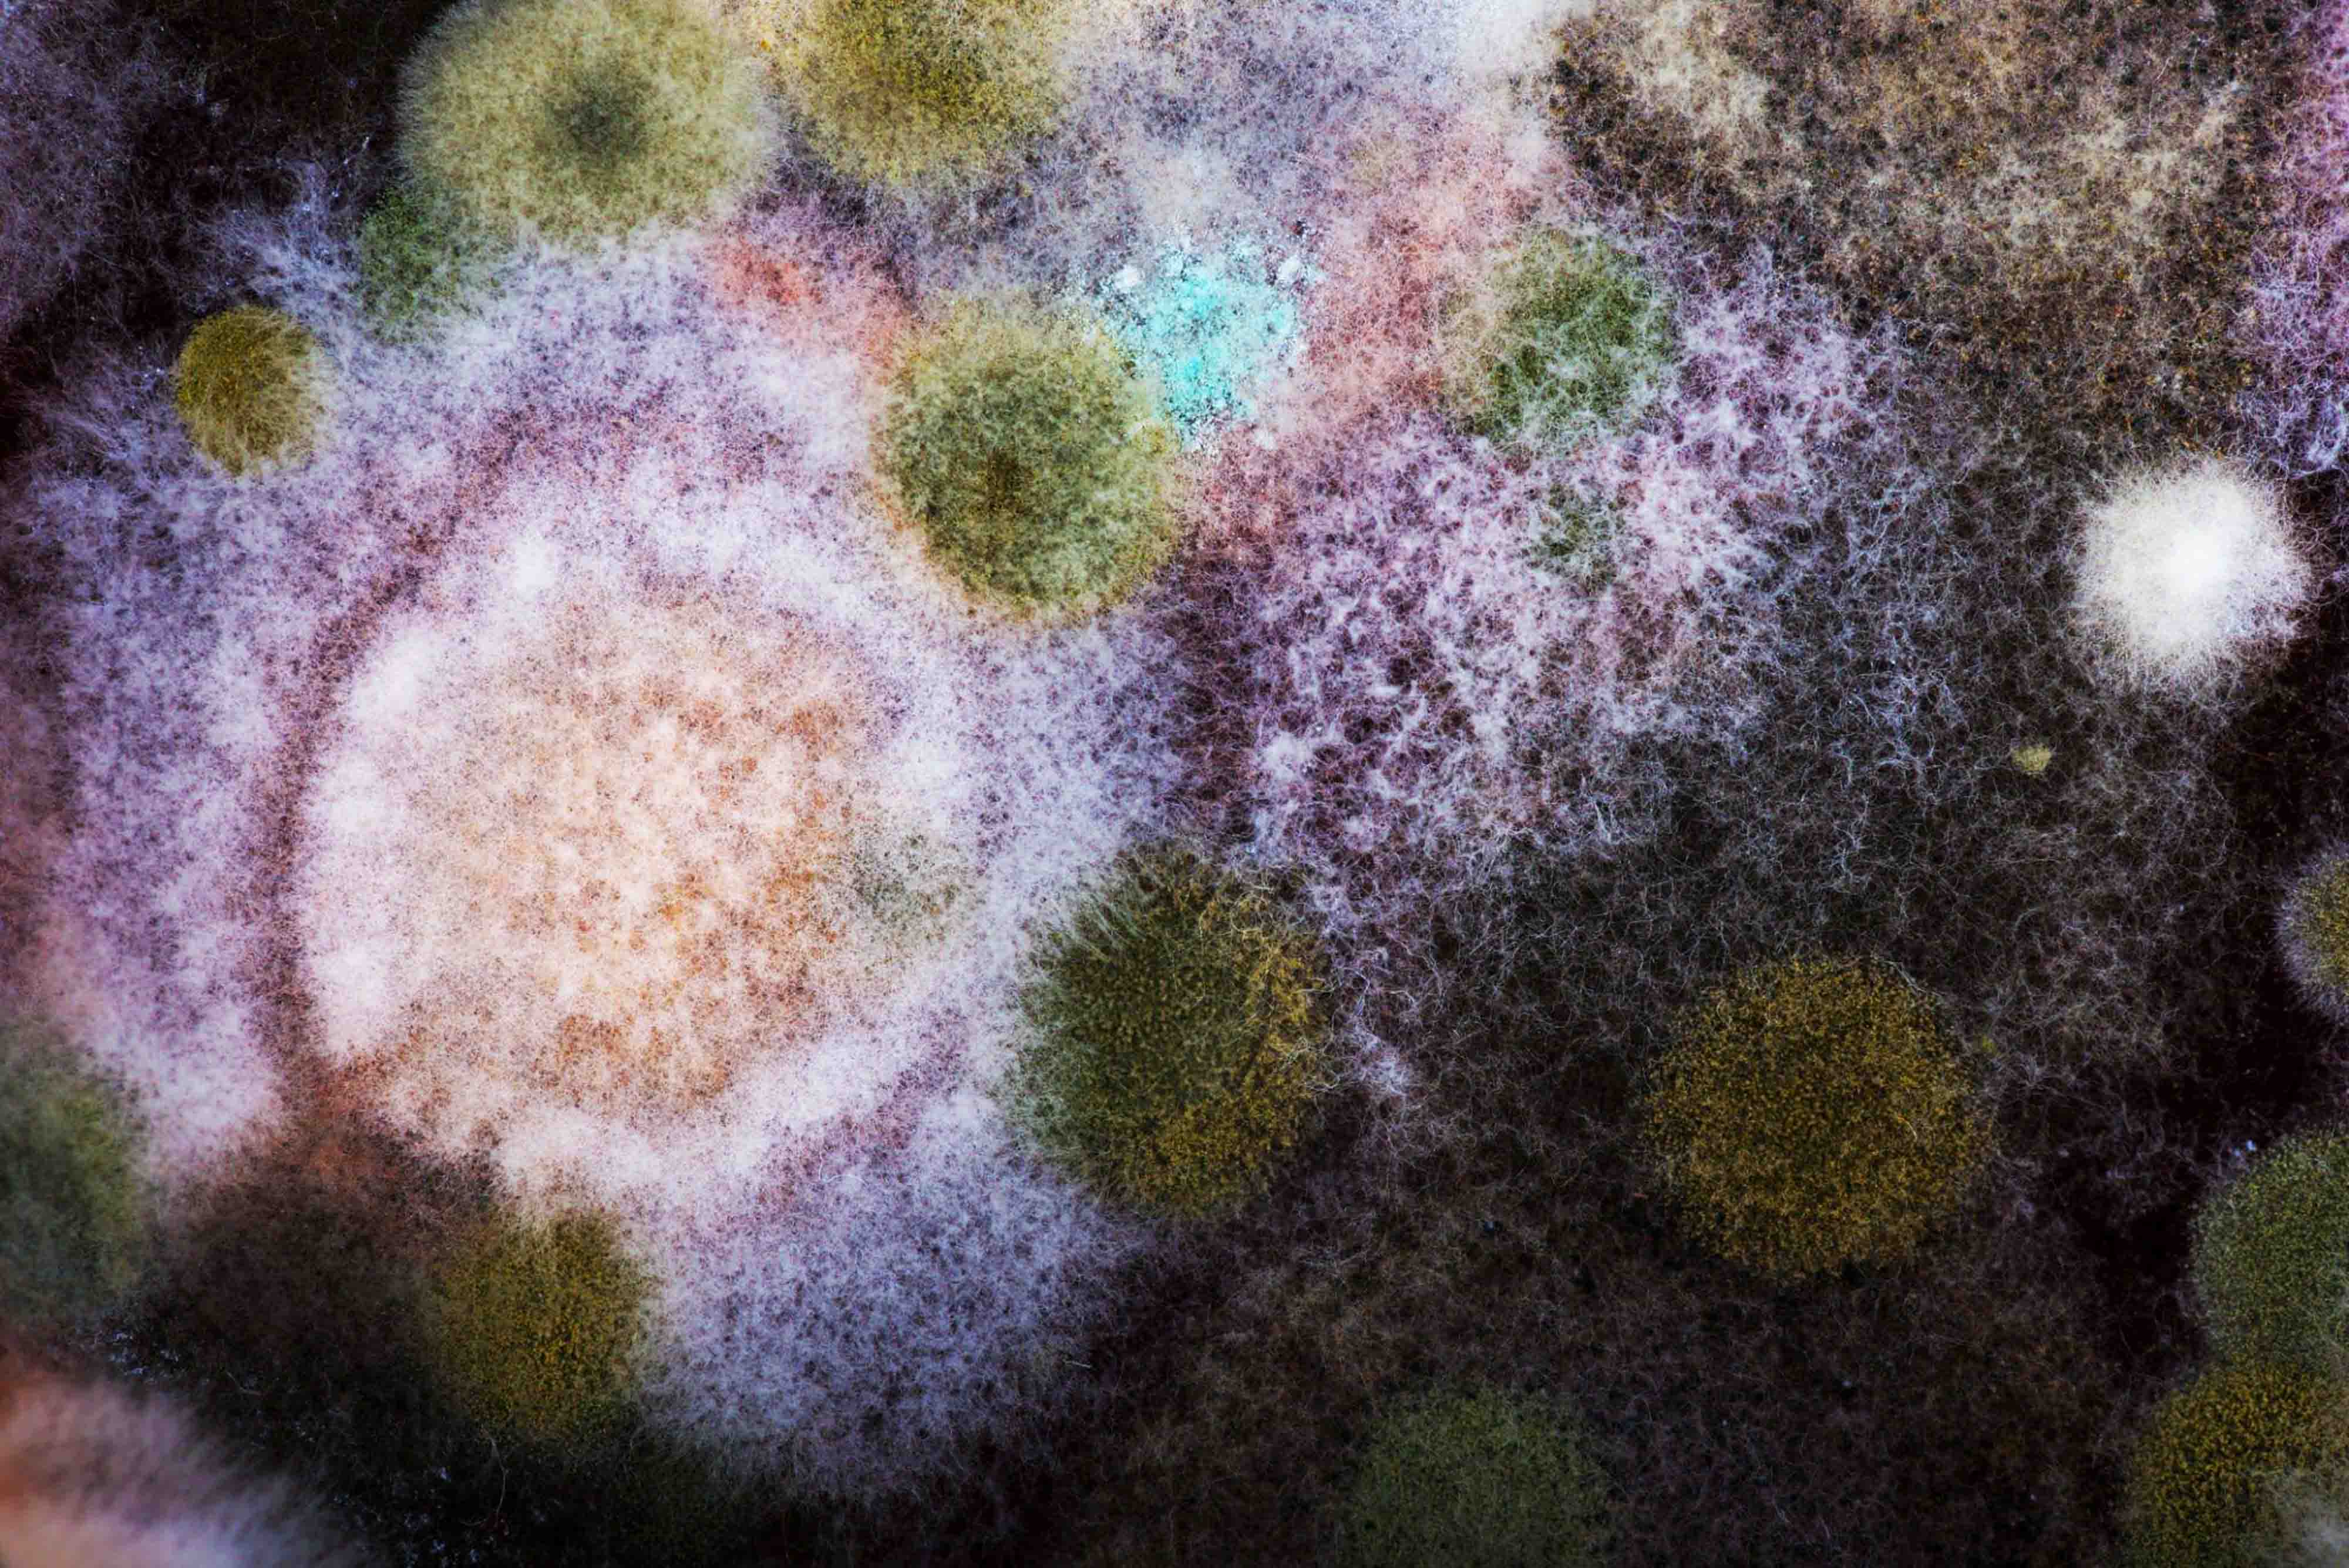

The skin is not just a surface that needs to be cared for – it is a living, sensitive system that protects you every day .
And he doesn't work alone.
Microscopic helpers live on its surface: bacteria, viruses, fungi - together forming what we call the microbiome .
What exactly is the skin microbiome?
The microbiome is your skin's own "ecosystem" – a community of billions of microorganisms that:
-
helps protect the skin from pathogens
-
regulates inflammatory processes
-
supports the skin's natural pH value
-
and is even related to the immune system
Simpler?
It's like you have an invisible, good-natured skin care team that can work well even if you don't clean your skin thoroughly, for example.
What happens if this balance is upset?
The microbiome is vulnerable .
Modern lifestyles and certain beauty habits can easily throw off the balance. Some common triggers include:
-
Too frequent or too vigorous facial cleansing
-
Regular use of alcohol-based antibacterial products
-
Stress and lack of sleep
-
Antibiotic treatment
-
Polluted city air
-
Poorly chosen cosmetics
Result:
-
Harmful bacteria (e.g. Cutibacterium acnes) may multiply
-
The skin's defenses are weakened.
-
Inflammation, irritation and acne may develop
At this point, most people try to "treat" the problem even more aggressively - which unfortunately only makes the situation worse.
The solution: work with your skin
If you can restore the natural balance of your microbiome, your skin will be able to function confidently again – without inflammation.
TUUMBIOME Acne Care Phage Gel helps restore the skin's natural defenses .
It contains live bacteriophages that specifically destroy acne-causing bacteria.
What can you do for your skin's microbiome?
5 scientifically based, simple steps
1. Avoid aggressive cleaning
You don't need to wash your face too often – especially not with alcohol-based, antibacterial cleansers. In the morning, for example, just wash it with water, as the skin doesn't get as dirty at night as it does during the day – it's not exposed to makeup, sunlight, smog, and you don't touch it with dirty hands. During the night, the skin regenerates and the microbiome rebuilds. If you start doing this in the morning, you'll also reset the natural protection built up overnight.
👉 Use a gentle, pH-balanced cleanser (approx. pH 5.5), once a day is enough.
2. Don't let your skin dry out
Dry skin encourages the growth of harmful bacteria. Proper hydration strengthens the skin's protective layer.
👉 Use a water-based, fragrance-free moisturizer.
3. Don't use an antibacterial routine unless you have to
Antibacterial ingredients (e.g. benzoyl peroxide, triclosan) kill indiscriminately and can disrupt the microbiome in the long term.
👉 Choose a targeted solution, such as phage technology, which only destroys acne-causing bacteria .
4. Build a simple, stable routine
The microbiome works well if you don't constantly change its conditions .
👉 Don't change your creams every week. Give your skin time to adapt (approx. 3–6 weeks).
5. Give your skin time to regenerate
Rebuilding the microbiome doesn't happen overnight .
👉 If you are using a new microbiome-friendly product, keep the routine for at least 4-8 weeks - this corresponds to one skin renewal cycle.
Why is the TUUMBIOME approach special?
TUUMBIOME does not offer symptomatic treatment, but rather science-based support for the skin's natural defenses. The live phages it contains:
-
they only attack harmful bacteria
-
they do not affect beneficial members of the microbiome
-
they do not dry or irritate
-
also suitable for sensitive skin
This type of precision skincare could be the new standard for natural, effective, and microbiome-friendly acne treatment.
Targeted help for your skin – naturally
If you're looking for a skin care solution that's effective, gentle, and scientifically proven, try T UUMBIOME Acne Care Phage Gel .